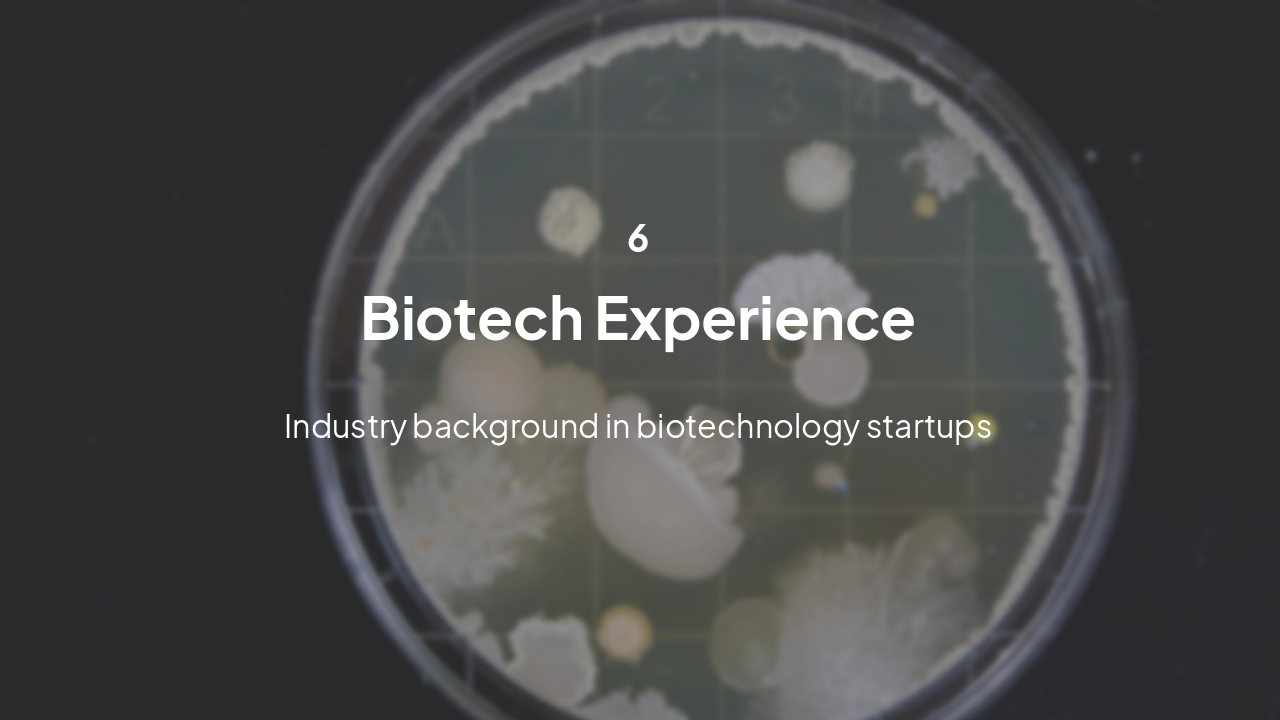
Slide 19 - Biotech Experience

Slide 1 - The ADAMTS Gene Family of Nematostella vectensis
The ADAMTS Gene Family of Nematostella vectensis
Benjamin Kimelfeld Bollyky Lab Meeting – Feb 19, 2026
---
Photo by Default Cameraman on Unsplash

Generated from prompt:
Redesign and enhance the uploaded presentation titled "Bollyky Lab Meeting Feb-19-2026 – Benjamin Kimelfeld" using a Dark Research Conference Theme. Design Requirements: - Background: deep charcoal / navy gradient - Accent color: neon cyan / teal - Clean, modern, high-contrast scientific aesthetic - Subtle molecular / network texture in corners (low opacity) - Section divider slides with bold glowing titles - Consistent typography (modern sans-serif) - Rounded white containers with soft shadows for figures - Footer: Lab name | Date | Slide number Content Structure (preserve and improve clarity, formatting, and visual hierarchy): 1. Title Slide - The ADAMTS Gene Family of Nematostella vectensis - Benjamin Kimelfeld - Bollyky Lab Meeting – Feb 19, 2026 2. Themes of Presentation - Nematostella as a model organism - Characterization of Nv-ADAMTS genes - Phylogenetics + domain architecture - Development & regeneration expression - Focus on Nv-ADAMTS1, 6, 14, 19 --- Section Divider --- Nematostella vectensis: A Basal Metazoan Model 3. Life Cycle & Morphology 4. Whole-Body Regeneration & Experimental Tools --- Section Divider --- ADAMTS Proteases Background 5. ADAMTS Modular Structure 6. ADAMTS Clades & Vertebrate Functions 7. ADAMTS in Cnidarians – Open Questions --- Section Divider --- Nv-ADAMTS Family Analysis 8. Identifying Nv-ADAMTS Homologues 9. Motif Conservation 10. Phylogenetic Pipeline 11. Shifting ADAMTS Clade Origins --- Section Divider --- Expression Analysis 12. Spatiotemporal Expression Experiments 13. Spatial Expression – 4 Body Parts 14. Spatial Expression – 3 Body Parts 15. Developmental Expression 16. Regeneration Expression 17. In-Situ Hybridization 18. ChIP-seq for ADAMTS1 & 6 --- Section Divider --- Summary 19. Key Findings Summary --- Section Divider --- Biotech Experience 20. GAIA Biotechnologies 21. EFA Technologies 22. Red C Biotech --- Section Divider --- Bollyky Lab Work 23. Phage Biology & Gene Delivery 24. Preliminary Results 25. Thank You / Questions Enhance slide clarity by: - Converting dense paragraphs to structured bullet points - Adding bold takeaway statements to data-heavy slides - Improving hierarchy and spacing - Ensuring visual consistency throughout Make the presentation conference-ready and visually striking.
This presentation details the ADAMTS gene family in the cnidarian model Nematostella vectensis, covering its identification, phylogenetics, domain architecture, expression during development and regeneration, key findings on basal origins, and the现er
The ADAMTS Gene Family of Nematostella vectensis
Benjamin Kimelfeld Bollyky Lab Meeting – Feb 19, 2026
---
Photo by Default Cameraman on Unsplash


1
A cnidarian model organism for studying evolution, regeneration, and development
---
Photo by Jake F on Unsplash


---
Photo by Ian Talmacs on Unsplash

2
Understanding modular structure, clades, and roles in cnidarians
---
Photo by Default Cameraman on Unsplash

---
Photo by ilgmyzin on Unsplash


3
Identifying and characterizing homologues in N. vectensis
---
Photo by GuerrillaBuzz on Unsplash


| Step | Description |
|---|---|
| 1. Homologue collection | BLAST/HMMER across metazoans |
| 2. Multiple sequence alignment | MAFFT or MUSCLE |
| 3. Model selection | ProtTest / IQ-TREE |
| 4. Tree inference | RAxML / IQ-TREE maximum likelihood |
| 5. Clade annotation | Reference vertebrate clades |

---
Photo by Niall Smith on Unsplash

4
Developmental, spatial, and regeneration expression of Nv-ADAMTS genes
---
Photo by Logan Voss on Unsplash



---
Photo by John A Garrison Jr on Unsplash

5
ADAMTS evolution and function in a basal metazoan
---
Photo by Klara Kulikova on Unsplash


6
Industry background in biotechnology startups
---
Photo by Michael Schiffer on Unsplash
🧬 GAIA Biotechnologies Synthetic biology & gene editing platforms
🔬 EFA Technologies Enzyme engineering for therapeutics
💉 Red C Biotech Cell therapy & regenerative medicine

Phage Biology & Gene Delivery Preliminary Results Promising
Thank You! Questions?
Joining Bollyky Lab to explore phage-based delivery for ADAMTS modulation

Explore thousands of AI-generated presentations for inspiration
Generate professional presentations in seconds with Karaf's AI. Customize this presentation or start from scratch.